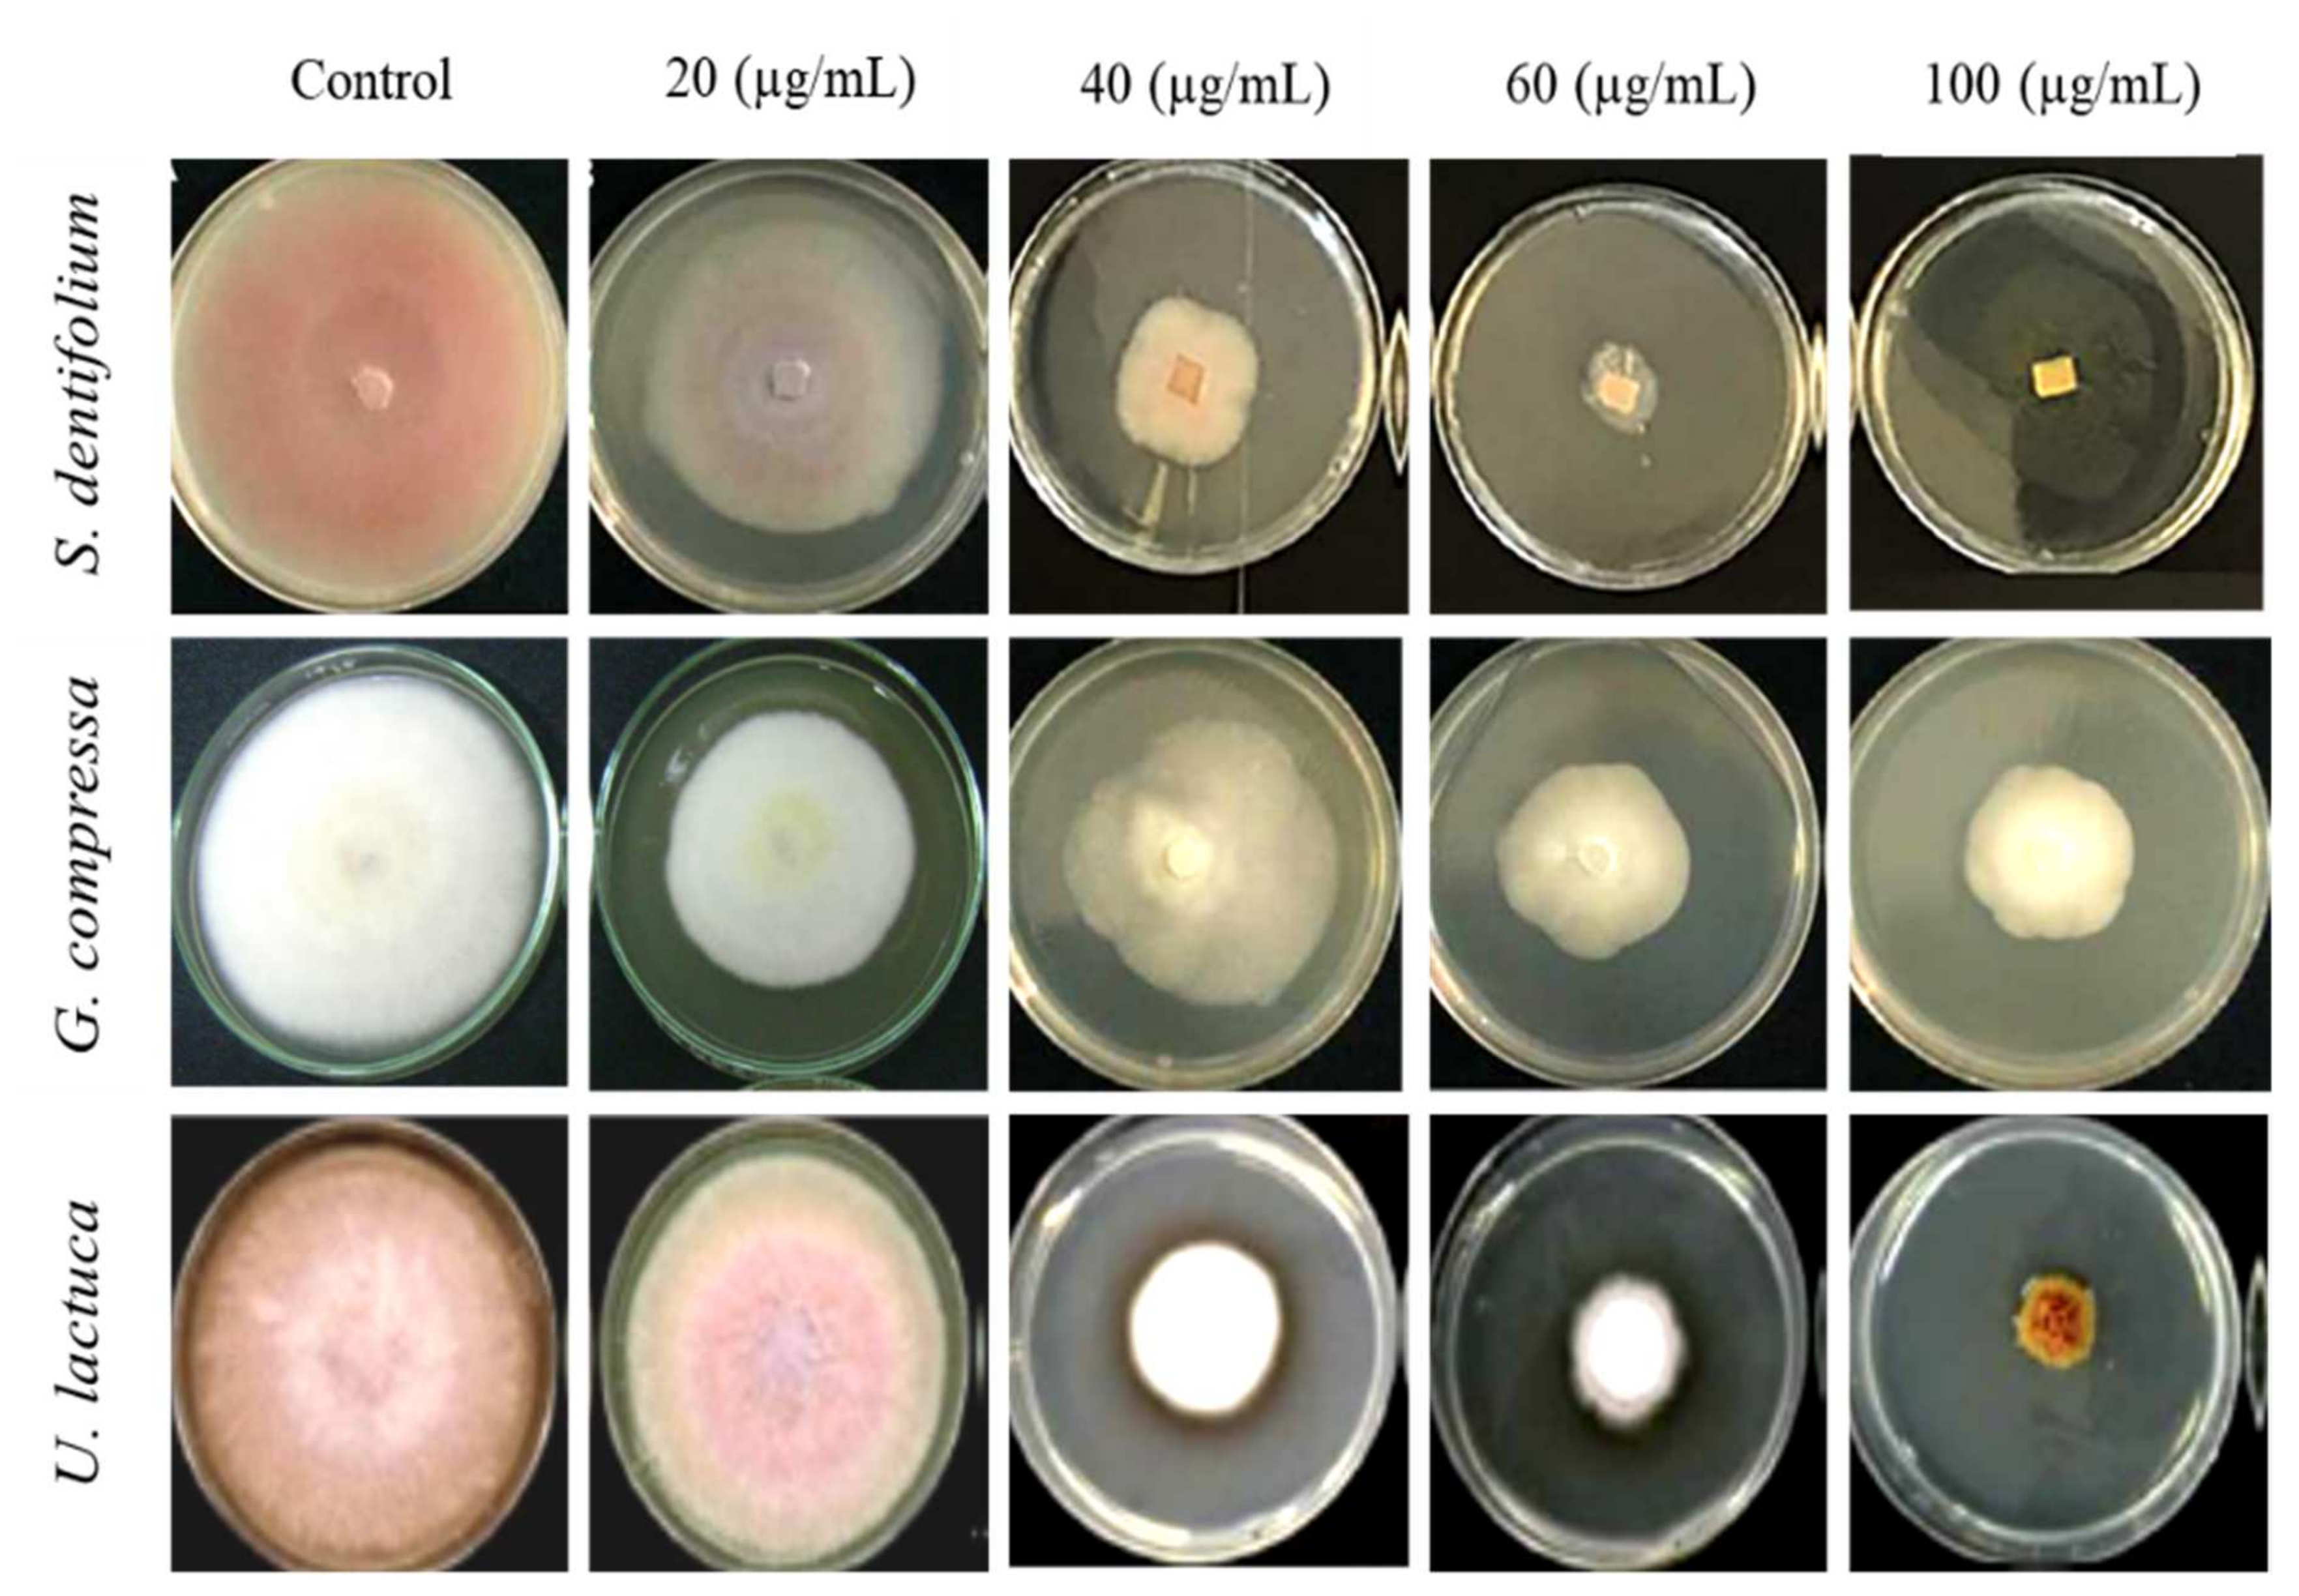
Agriculture 12 00345 g005

In Vitro and In Vivo Biocontrol of Tomato Fusarium Wilt by Extracts from Brown, Red, and Green Macroalgae
Abstract
:1. Introduction
2. Materials and Methods
2.1. Isolation of Fusarium from Infected Tomato Plants and Pathogenicity Testing
2.2. Pathogen Identification
2.2.1. Characteristics of Culture and Morphology of Fusarium Isolates
2.2.2. Identification of Fusarium Isolates by Molecular Technique
DNA Extraction
Polymerase Chain Reaction (PCR)
2.3. Sampling of Macroalgae
2.4. Preparation of Algal Extracts
2.5. Antifungal Activity of Algal Extracts In Vitro
2.6. Determination of Total Phenolic Content
2.7. Determination of Phenolic Compounds by High-Performance Liquid Chromatography (HPLC)
2.8. Scanning Electron Microscopy (SEM)
2.9. Greenhouse Experiment
2.10. Effect of Algal Extract of S. dentifolium on Disease Assessment and Fruit Yield
2.11. Data Analysis
3. Results
3.1. Characteristics of Culture and Morphology of Fusarium Isolates
3.2. Growth Rate and Radial Growth of FOL Isolates
3.3. Molecular Characterization of Fusarium Isolates
3.4. Pathogenicity Testing
3.5. Effect of Algal Extracts on Linear Mycelial Growth of FOL In Vitro
3.6. Total Phenolic Content
3.7. Quantitative Phenolic Compounds Using HPLC
3.8. Scanning Electron Microscopy
3.9. Effect of Algal Powder of S. dentifolium on Disease Severity and Fruit Yield
4. Discussion
5. Conclusions
Author Contributions
Funding
Institutional Review Board Statement
Informed Consent Statement
Data Availability Statement
Acknowledgments
Conflicts of Interest
References
- Al-Askar, A.A.; Ghoneem, K.M.; Rashad, Y.M.; Abdulkhair, W.M.; Hafez, E.E.; Shabana, Y.M.; Baka, Z.A. Occurrence and distribution of tomato seed-borne mycoflora in Saudi Arabia and its correlation with the climatic variables. Microb. Biotechnol. 2014, 7, 556–569. [Google Scholar] [CrossRef] [PubMed]
- Food and Agriculture Organization of the United Nations. Food and Agriculture Database. Available online: https://www.fao.org/faostat (accessed on 15 December 2018).
- El-Komy, M.H.; Saleh, A.A.; Ibrahim, Y.E.; Hamad, Y.K.; Molan, Y.Y. Trichoderma asperellum strains confer tomato protection and induce its defense-related genes against the Fusarium wilt pathogen. Trop. Plant Pathol. 2016, 41, 277–287. [Google Scholar] [CrossRef]
- Hibar, K.; Daami-Remadi, M.; Hamada, W.; El-Mahjoub, M. Biofungicides as an alternative for tomato Fusarium crown and root rot control. Tunis. J. Plant Prot. 2006, 1, 19–29. [Google Scholar]
- Finckh, M.R.; van Bruggen, A.H.C.; Tamm, L. Plant diseases and their management in organic agriculture; APS Press: Saint Paul, MN, USA, 2015; p. 414. [Google Scholar]
- Sharma, O.P.; Pruthi, S.; Mohan, G.; Kaur, M.; Kumari, M. Assessment of fungicides against the early blight of tomato induced by Alternaria solani (Ellis & Martin) under field conditions. Int. J. Chem. Stud. 2020, 8, 693–696. [Google Scholar]
- Recep, K.; Fikrettin, S.; Erkol, D.; Cafer, E. Biological control of the potato dry rot caused by Fusarium species using PGPR strains. Biol. Control 2009, 50, 194–198. [Google Scholar] [CrossRef]
- Yang, R.-Y.; Li, C.-Y.; Lin, Y.-C.; Peng, G.-T.; She, Z.-G.; Zhou, S.-N. Lactones from a brown alga endophytic fungus (No. ZZF36) from the South China Sea and their antimicrobial activities. Bioorganic Med. Chem. Lett. 2006, 16, 4205–4208. [Google Scholar] [CrossRef] [PubMed]
- Orandy, M.A.; Verde, M.J.; Martinez-Lozano, S.J.; Waksman, N.H. Active fractions from species of marine algae. Intern. J. Exp. Bot. 2004, 73, 165–170. [Google Scholar]
- Pourakbar, L.; Moghaddam, S.S.; El Enshasy, H.A.; Sayyed, R.Z. Antifungal activity of the extract of macroalgae, Gracilariopsis persica, against four plant pathogenic fungi. Plants 2021, 10, 1781. [Google Scholar] [CrossRef]
- Kausalya, M.; Narasimha Rao, G.M. Antimicrobial activity of marine algae. J. Algal Biomass Utln. 2015, 6, 78–87. [Google Scholar]
- Martin, M.K. The potential for using cyanobacteria (blue-green algae) and algae in the biological control of plant pathogenic bacteria and fungi. Eur. J. Plant Pathol. 1995, 101, 585–599. [Google Scholar]
- Hellio, C.; Bremer, G.; Pons, A.M.; Le Gal, Y.; Bourgougnon, N. Inhibition of the development of microorganisms (bacteria and fungi) by extracts of marine algae from Brittany, France. Appl. Microbiol. Biotechnol. 2000, 54, 543–549. [Google Scholar] [CrossRef] [PubMed]
- Yi, Z.; Yin-Shan, C.; Hai-Sheng, L. Screening for antibacterial and antifungal activities in some marine algae from the Fujian coast of China with three different solvents. Chin. J. Oceanol. Limnol. 2001, 19, 327–331. [Google Scholar] [CrossRef]
- Khanzada, A.K.; Shaikh, W.; Kazi, T.G.; Kabir, S.; Soofia, S. Antifungal activity, elemental analysis and determination of total protein of seaweed, Solieria robusta (Greville) Kylin from the coast of Karachi. Pak. J. Bot. 2007, 39, 931–937. [Google Scholar]
- Perez, J.C.F.; de Carvalho, L.R.; Gonçalez, E.; Berian, L.O.S.; Felicio, J.D. Evaluation of antifungal activity of seaweed extracts. Ciência E Agrotecnologia 2012, 36, 294–299. [Google Scholar]
- El-Sheekh, M.M.; Mousa, A.S.H.; Farghl, A.A.M. Biological Control of Fusarium Wilt Disease of Tomato Plants Using Seaweed Extracts. Arab. J. Sci. Eng. 2020, 45, 4557–4570. [Google Scholar] [CrossRef]
- Tsegaye, M.; Tesfaye, A. Morphological and molecular diversity of Fusarium species causing wilt disease in ginger (Zingiber officinale Roscoe) in South-Western Ethiopia. Singap. J. Sci. Res. 2020, 10, 342–356. [Google Scholar]
- Leslie, J.F.; Summerell, B.A. The fusarium laboratory manual; Blackwell Publishing: Hoboken, NJ, USA, 2006. [Google Scholar]
- El-Said, G.F.; El-Sikaily, A. Chemical composition of some seaweed from Mediterranean Sea coast, Egypt. Environ. Monit. Assess. 2012, 185, 6089–6099. [Google Scholar] [CrossRef] [Green Version]
- Kumar, C.S.; Dronamraju, V.; Sarada, L.; Ramasamy, R. Seaweed extracts control the leaf spot disease of the medicinal plant Gymnema sylvestre. Indian J. Sci. Technol. 2008, 1, 1–5. [Google Scholar] [CrossRef]
- Singh, L.; Tripathi, N.N. Inhibition of storage fungi of black gram (Vigna mungo) by some essential oils. Flavour Fragr. J. 1999, 14, 1–4. [Google Scholar] [CrossRef]
- Sanoner, P.; Guyot, S.; Marnet, N.; Molle, D.; Drilleau, J.-F. Polyphenol Profiles of French Cider Apple Varieties (Malus domestica sp.). J. Agric. Food Chem. 1999, 47, 4847–4853. [Google Scholar] [CrossRef]
- Sultana, V.; Haque, S.E.; Baloch, G.N.; Ara, J. Comparative efficacy of a red alga Solieria robusta, chemical fertilizers and pes-ticides in managing the root diseases and growth of soybean. Pak. J. Bot. 2011, 43, 1–6. [Google Scholar]
- Murugan, L.; Krishnan, N.; Venkataravanappa, V.; Saha, S.; Mishra, A.K.; Sharma, B.K.; Rai, A.B. Molecular characterization and race identification of Fusarium oxysporum f. sp. lycopersici infecting tomato in India. 3 Biotech 2020, 10, 486. [Google Scholar] [CrossRef] [PubMed]
- Cai, G.; Gale, L.R.; Schneider, R.W.; Kistler, H.C.; Davis, R.M.; Elias, K.S.; Miyao, E.M. Origin of Race 3 of Fusarium oxysporum f. sp. lycopersici at a Single Site in California. Phytopathology 2003, 93, 1014–1022. [Google Scholar] [CrossRef] [PubMed] [Green Version]
- Rozlianah, F.S.; Sariah, M. Characterization of Malaysian isolates of Fusarium from tomato and pathogenicity testing. Res. J. Microbiol. 2006, 1, 266–272. [Google Scholar]
- Vignesh, K.; Rajamohan, K.; Anandan, P.; Udhayakumar, R. Morphological and molecular variation of Fusarium ovysporum f. sp. lycopersici isolates causing wilt in tomato. Plant Arch. 2021, 21, 2363–2368. [Google Scholar]
- Okayo, R.O.; Andika, D.O.; Dida, M.M.; K’Otuto, G.O.; Gichimu, B.M. Morphological and Molecular Characterization of Toxigenic Aspergillus flavus from Groundnut Kernels in Kenya. Int. J. Microbiol. 2020, 2020, 8854718. [Google Scholar] [CrossRef]
- Joshi, M.; Srivastava, R.; Sharma, A.K.; Prakash, A. Isolation and characterization of Fusarium oxysporum, a wilt causing fungus, for its pathogenic and non-pathogenic nature in tomato (Solanum lycopersicum). J. Appl. Nat. Sci. 2013, 5, 108–117. [Google Scholar] [CrossRef] [Green Version]
- NirmalaDevi, D.; Venkataramana, M.; Srivastava, R.K.; Uppalapati, S.R.; Gupta, V.K.; Yli-Mattila, T.; Tsui, C.; Srinivas, C.; Niranjana, S.R.; Chandra, N.S. Molecular phylogeny, pathogenicity and toxigenicity of Fusarium oxysporum f. sp. lycopersici. Sci. Rep. 2016, 6, 21367. [Google Scholar] [CrossRef] [Green Version]
- Hlaiem, S.; Della Rocca, G.; Barberini, S.; Danti, R.; Ben Jamâa, M.L. Morphological and molecular identification of Fusarium oxysporum f. sp. lycopersici associated with Olea europaea var. sylvestris decline phenomenon in Tunisia. Plant Pathol. Quar. 2021, 11, 15–22. [Google Scholar] [CrossRef]
- Pothiraj, G.; Hussain, Z.; Singh, A.K.; Solanke, A.U.; Aggarwal, R.; Ramesh, R.; Shanmugam, V. Characterization of Fusarium spp. inciting vascular wilt of tomato and its management by Chaetomium-based biocontrol consortium. Front. Plant Sci. 2021, 12, 748013. [Google Scholar] [CrossRef]
- Chaerani, R.; Voorrips, R.E. Tomato early blight (Alternaria solani): The pathogen, genetics, and breeding for resistance. J. Gen. Plant Pathol. 2006, 72, 335–347. [Google Scholar] [CrossRef]
- McDonald, B.A.; Linde, C. Pathogen population genetics, evolutionary potential and durable resistance. Annu. Rev. Phytopathol. 2002, 40, 349–379. [Google Scholar] [CrossRef] [PubMed] [Green Version]
- van der Waals, J.E.; Korsten, L.; Slippers, B. Genetic diversity among Alternaria solani isolates from potatoes in South Africa. Plant Dis. 2004, 88, 959–964. [Google Scholar] [CrossRef] [PubMed] [Green Version]
- Johnsi Christoble, G.; Lipton, A.P.; Aishwarya, M.S.; Sarika, A.R.; Udayakumar, A. Antibacterial activity of aqueous extract from selected macroalgae of southwest coast of India. Seaweed Res. Utiln. 2011, 33, 67–75. [Google Scholar]
- Soliman, A.S.; Ahmed, A.Y.; Abdel-Ghafour, A.; El-Sheekh, M.; Sobhy, H. Antifungal bio-efficacy of the red algae Gracilaria confervoides extracts against three pathogenic fungi of the cucumber plant. Middle East. J. Appl. 2018, 8, 727–735. [Google Scholar]
- Kim, S.-K.; Karadeniz, F. Anti-HIV activity of extracts and compounds from marine algae. Adv. Food Nutr. Res. 2011, 64, 255–265. [Google Scholar]
- Zarei Jeliani, Z.; Mashjoor, S.; Soleimani, S.; Pirian, K.; Sedaghat, F. Antioxidant activity and cytotoxicity of organic extracts from three species of green macroalgae of Ulvaceae from Persian Gulf. Modares J. Biotech. 2018, 9, 59–67. [Google Scholar]
- Abdelhamid, A.; Jouini, M.; Bel Haj Amor, H.; Mzoughi, Z.; Dridi, M.; Ben Said, R.; Bouraoui, A. Phytochemical analysis and evaluation of the antioxidant, anti-inflammatory, and anti-nociceptive potential of phlorotannin-rich fractions from three Mediterranean brown seaweeds. Mar. Biotechnol. 2018, 20, 60–74. [Google Scholar] [CrossRef]
- Omar, H.H.; Gumgumji, N.M.; Shiek, H.M.; El-Kazan, M.M.; El-Gendy, A.M. Inhibition of the development of pathogenic fungi by extracts of some marine algae from the red sea of Jeddah, Saudi Arabia. Afr. J. Biotechnol. 2012, 11, 13697–13704. [Google Scholar]
- Hussain, H.I.; Kasinadhuni, N.; Arioli, T. The effect of seaweed extract on tomato plant growth, productivity and soil. J. Appl. Phycol. 2021, 33, 1305–1314. [Google Scholar] [CrossRef]
- Vicente, T.F.L.; Lemos, M.F.L.; Félix, R.; Valentão, P.; Félix, C. Marine Macroalgae, a Source of Natural Inhibitors of Fungal Phytopathogens. J. Fungi 2021, 7, 1006. [Google Scholar] [CrossRef] [PubMed]
- Manivannan, K.; Karthikai devi, G.; Anantharaman, P.; Balasubramanian, T. Antimicrobial potential of selected brown seaweeds from Vedalai coastal waters, Gulf of Mannar. Asian Pac. J. Trop. Biomed. 2011, 1, 114–120. [Google Scholar] [CrossRef] [Green Version]
- Murakami, M.; Makabe, K.; Yamaguchi, K.; Konosu, S.; Walehli, M.R.; Goniodomin, A. A novel polyether macrolide from the dinoflagellate Goniodoma pseudogonyaulax. Tetrahedron Lett. 1988, 29, 1149–1152. [Google Scholar] [CrossRef]
- Elkhateeb, M.I.; El-Bitar, A.M.H.; Saleh, S.R.; Abdelreheem, A.M.A. Evaluation of bioactive phytochemical characterization, antioxidant, antimicrobial, and antihemolytic properties of some seaweeds collected from Red Sea coast, Egypt. Egypt. J. Aquat. Biol. Fish. 2021, 25, 417–436. [Google Scholar] [CrossRef]
- Generali’c Mekini’c, I.; Skroza, D.; Šimat, V.; Hamed, I.; Cagalj, M.; Popovi’c Perkovi’c, Z. Phenolic content of brown algae (pheophyceae) species: Extraction, identification, and quantification. Biomolecules 2019, 9, 244. [Google Scholar] [CrossRef] [Green Version]
- Sang, V.T.; Hung, N.D.; Se-Kwon, K. Pharmaceutical properties of marine polyphenols: An overview. Acta Pharm. Sci. 2019, 57, 217. [Google Scholar] [CrossRef] [Green Version]
- Imbs, T.I.; Zvyagintseva, T.N. Phlorotannins are Polyphenolic Metabolites of Brown Algae. Russ. J. Mar. Biol. 2018, 44, 263–273. [Google Scholar] [CrossRef]
- Bogolitsyn, K.; Druzhinina, A.; Kaplitsin, P.; Ovchinnikov, D.; Parshina, A.; Kuznetsova, M. Relationship between radical scavenging activity and polymolecular properties of brown algae polyphenols. Chem. Pap. 2019, 73, 2377–2385. [Google Scholar] [CrossRef]
- Bhattacharya, A.; Sood, P.; Citovsky, V. The roles of plant phenolics in defense and communication during Agrobacterium and Rhizobium infection. Mol. Plant Pathol. 2010, 11, 705–719. [Google Scholar]
- Farkas, G.L.; Kiraaly, Z. Role of phenolic compounds in the physiology of plant diseases and disease resistance. J. Phytopathol. 1962, 44, 105–150. [Google Scholar] [CrossRef]
- Lattanzio, V.; Lattanzio, V.M.T.; Cardinali, A. Role of phenolics in the resistance mechanisms of plants against fungal pathogens and insects. In Phytochemistry Advances in Research; Imperato, F., Ed.; Research Signpost: Kerala, India, 2006; pp. 23–67. [Google Scholar]
- Nguyen, D.-M.; Seo, D.-J.; Lee, H.-B.; Kim, I.-S.; Kim, K.-Y.; Park, R.-D.; Jung, W.-J. Antifungal activity of gallic acid purified from Terminalia nigrovenulosa bark against Fusarium solani. Microb. Pathog. 2013, 56, 8–15. [Google Scholar] [CrossRef] [PubMed]
- El-Nagar, A.; Elzaawely, A.A.; Taha, N.A.; Nehala, Y. The antifungal activity of gallic acid and its derivatives against Alternaria solani, the causal agent of tomato early blight. Agronomy 2020, 10, 1402. [Google Scholar] [CrossRef]
- Vio-Michaelis, S.; Apablaza-Hidalgo, G.; Gomez, M.; Pena-Vera, P.; Montenegro, G. Antifungal activity of three Chilean plant extracts on Botrytis cinerea. Bot. Sci. 2012, 90, 179–183. [Google Scholar] [CrossRef]
- Karou, D.; Dicko, M.H.; Simpore, J.; Traore, A.S. Antioxidant and antibacterial activities of polyphenols from ethnomedicinal plants of Burkina Faso. Afr. J. Biotechnol. 2005, 4, 823–828. [Google Scholar]
- Papenfuss, G.F.; Taylor, W.R. Marine algae of the eastern tropical and subtropical coasts of the Americas. Bull. Torrey Bot. Club 1961, 88, 421. [Google Scholar] [CrossRef]
- Aleem, A.A. Contributions to the study of the marine algae of the Red Sea. New or little-known algae from the west coast of Saudi Arabia. Bull. Fac. Sci. KAUJ. 1981, 5, 1–49. [Google Scholar]
- Ambika, S.; Sujatha, K. Antifungal activity of aqueous and ethanol extracts of seaweeds against sugarcane red rot pathogen (Colletotrichum falcatum). Sci. Res. Essays 2015, 10, 232–235. [Google Scholar]
- Rupapara, K.V.; Joshi, N.H.; Vyas, K.G. Evaluation of the antimicrobial activity of crude extracts of seaweed Sargassum johnstonii. Int. J. Curr. Microbiol. App. Sci. 2015, 4, 300–304. [Google Scholar]
- Begum, A.J.; Selvaraju, P.; Vijayakumar, A. Evaluation of antifungal activity of seaweed extract (Turbinaria conoides) against Pythium aphanidermatum (edson) fitzp. Life Sci. Leafl. 2015, 63, 162–168. [Google Scholar]
- Yamunarani, K.; Jaganathan, R.; Bhaskaran, R.; Govindaraju, P.; Velazhahan, R. Induction of early blight resistance in tomato by Quercus infectoria gall extract in association with accumulation of phenolics and defense-related enzymes. Acta Physiol. Plant. 2004, 26, 281–290. [Google Scholar] [CrossRef]
- Singh, J.; Yadav, A.N. Natural Bioactive Products in Sustainable Agriculture; Springer Nature: Gateway East, Singapore, 2020; p. 370. [Google Scholar]
- Elansary, H.O.; Szopa, A.; Kubica, P.; Ekiert, H.; Ali, H.M.; Elshikh, M.S.; Abdel-Salam, E.M.; El-Esawi, M.; El-Ansary, D.O. Bioactivities of traditional medicinal plants in Alexandria. Evid. Based Complement. Altern. Med. 2018, 2018, 1463579. [Google Scholar] [CrossRef] [PubMed] [Green Version]
- Ali, N.; Farrell, A.; Ramsubhag, A.; Jayaraman, J. The effect of Ascophyllum nodosum extract on the growth, yield and fruit quality of tomato grown under tropical conditions. J. Appl. Phycol. 2015, 28, 1353–1362. [Google Scholar] [CrossRef]

| Groups | Isolate Code | Accession Number | Closest Match | Similarity to GenBank Accessions | Frequency (%) |
|---|---|---|---|---|---|
| 1 | F2, F3, F4 F7, F8 | MTCC8609 | Clone 108 | 99.85% | 14.18 |
| 2 | F5, F6, F9 | MTCC9912 | Clone 180 | 99.50% | 40.72 |
| 3 | F1, F10 | MTCC8611 | Clone 108 | 100% | 25.10 |
Publisher’s Note: MDPI stays neutral with regard to jurisdictional claims in published maps and institutional affiliations. |
© 2022 by the authors. Licensee MDPI, Basel, Switzerland. This article is an open access article distributed under the terms and conditions of the Creative Commons Attribution (CC BY) license (https://creativecommons.org/licenses/by/4.0/).
Share and Cite
Mostafa, Y.S.; Alamri, S.A.; Alrumman, S.A.; Hashem, M.; Taher, M.A.; Baka, Z.A. In Vitro and In Vivo Biocontrol of Tomato Fusarium Wilt by Extracts from Brown, Red, and Green Macroalgae. Agriculture 2022, 12, 345. https://doi.org/10.3390/agriculture12030345
Mostafa YS, Alamri SA, Alrumman SA, Hashem M, Taher MA, Baka ZA. In Vitro and In Vivo Biocontrol of Tomato Fusarium Wilt by Extracts from Brown, Red, and Green Macroalgae. Agriculture. 2022; 12(3):345. https://doi.org/10.3390/agriculture12030345
Chicago/Turabian StyleMostafa, Yasser S., Saad A. Alamri, Sulaiman A. Alrumman, Mohamed Hashem, Mostafa A. Taher, and Zakaria A. Baka. 2022. "In Vitro and In Vivo Biocontrol of Tomato Fusarium Wilt by Extracts from Brown, Red, and Green Macroalgae" Agriculture 12, no. 3: 345. https://doi.org/10.3390/agriculture12030345
APA StyleMostafa, Y. S., Alamri, S. A., Alrumman, S. A., Hashem, M., Taher, M. A., & Baka, Z. A. (2022). In Vitro and In Vivo Biocontrol of Tomato Fusarium Wilt by Extracts from Brown, Red, and Green Macroalgae. Agriculture, 12(3), 345. https://doi.org/10.3390/agriculture12030345







